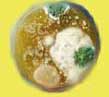

| Samleside: SPØR LEGEN - A |

Kan gravide drikke øl med inntil 0,7 prosent alkohol? Kan vi kjøre etter å ha drukket slikt øl? Huslegen i Puls svarer.
Spør Ørn
Muggsopp i huset kan utløse allergiske reaksjoner. Sporene til muggsoppen virvles opp i lufta, og pustes inn. Hva kan gjøres? Huslegen i Puls svarer.
"Vi vet at drinker aldri blir sunne, men stemmer det at alkohol faktisk ødelegger vitaminer og mineraler?"
Intensjonsavtalen mellom partene i arbeidslivet vil gjøre det lettere for bedrifter å beholde eller rekruttere utsatte arbeidstakere. Blant annet har det blitt enklere å bruke aktiv sykemelding.
Inkluderende Arbeidsliv -bedrift, hva innebærer det? PULS-legen, Ørn Terje Foss, svarer.
Utetrening i kulda - når er det for kaldt til å anbefale hard fysisk trening ute? PULS-legen, Ørn Terje Foss, svarer.
På en grillfest i sommer brant et barn seg på grillen. Moren smurte krem fra en aloe vera-plante på brannsåret og det så ut som om det virket. Hva tror du, Ørn?
Er det riktig at alkohol nedsetter virkningen av p-pillene?
Hva gjør man med pollenallergien når man er gravid/ammer og skal ta minst mulig medisiner?
Forsøk har vist at de som bruker glatte bomulls-T-skjorter drar med seg mindre allergener som de som bruker ull-gensere.
FLERE SAKER
|